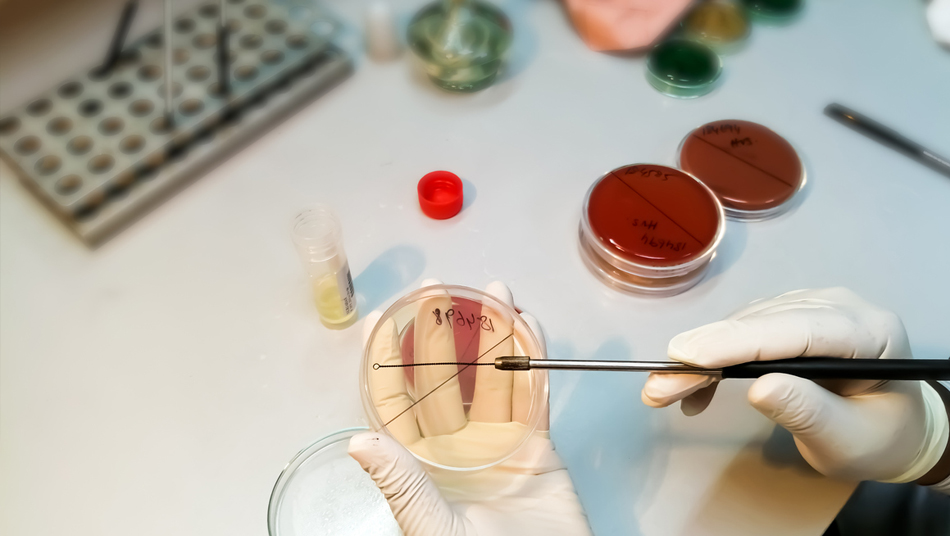

Noticias
Descubren un posible tratamiento para la resistencia a los antibióticos de las bacterias
20/12/2021
Los científicos han descubierto un nuevo tratamiento potencial que tiene la capacidad de revertir la resistencia a los antibióticos en las bacterias que causan afecciones como la sepsis, la neumonía y las infecciones del tracto urinario, según publican en la revista ‘Nature Chemistry’. Los carbapenems, como el meropenem, son un grupo de antibióticos vitales, a menudo de «último recurso», que se utilizan para tratar infecciones graves y multirresistentes cuando otros antibióticos, como la penicilina, han fallado. Pero algunas bacterias han encontrado una forma de sobrevivir también al tratamiento con carbapenems, produciendo unas enzimas que descomponen los antibióticos carbapenems, impidiendo su funcionamiento.
Fuente: Infosalus










